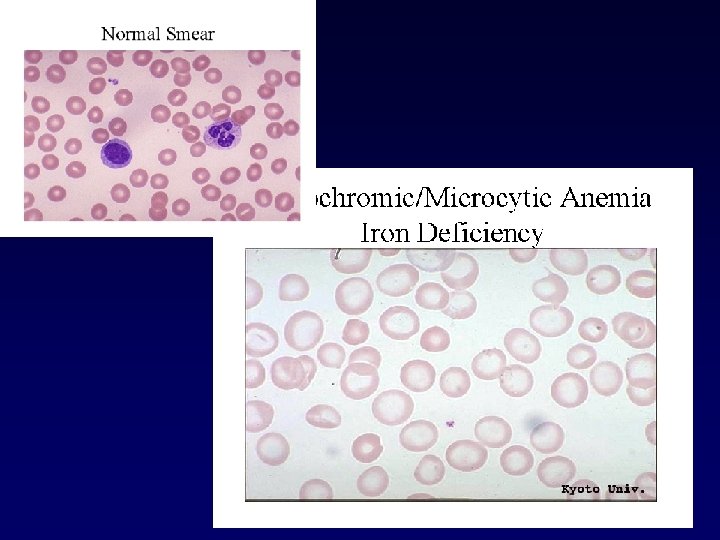
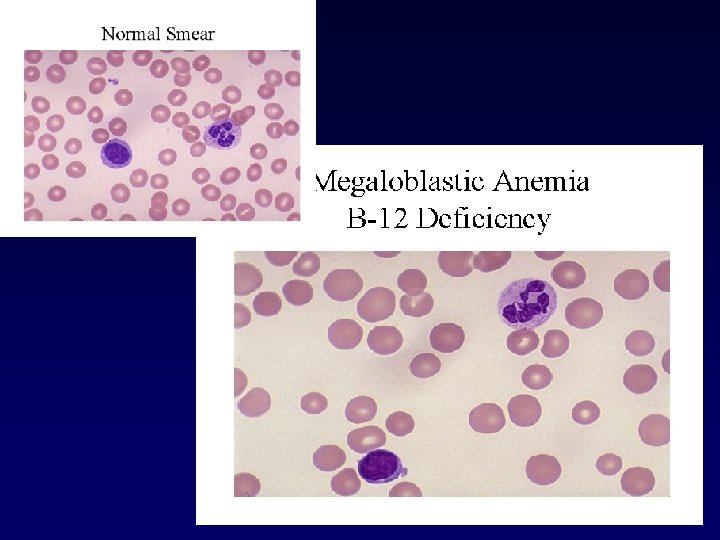

Hematologic examination Jan ivn Martin Vokurka Stanislav Matouek

- Slides: 68
Hematologic examination Jan Živný, Martin Vokurka, Stanislav Matoušek Department of Pathophysiology
Clinical signs of hematology diseases • Anemia → hypoxia signs – tiredness, weakness, lack of breath, paleness → cardiovascular symptoms – palpitation • Polycythemia → hyperviscose blood → risk of thrombosis • Bleeding, spontaneous bleeding, continuous bleeding • Thrombosis → embolia – symptoms depend on the localisation – DVT, pulmonary embolism • Frequent infections
Hematologic disease Leukemias etc. • Myelo-(proliferative) Disorders of Red Cells • Lympho- • Anemias • (granulo-, mono-) Hemostatic disorders • Primary hemostasis • Coagulation
MAIN REASONS OF HYPOXIA 1. 2. Lack of oxygen in inspired air / low oxygen partial pressure Respiratory failure • (= hypoxic hypoxia) 3. Lack of hemoglobin – oxygen transporter – (= anemic, transport hypoxia) 4. Circulation disorders (= circulatory hypoxia) – „lack of oxygen to the organs, tissues“ 5. Cell metabolism disorders (= histotoxic hypoxia)
Laboratory Tests Basic: • Complete blood count Specialized: • Tests for iron metabolism • Erythropoietin measurements • Detection of antibodies to self antigens (e. g. RBC) • Histochemical analysis of cell enzymatic activity • Cytogenetic and known mutation analysis Immunophenotyping of BM or PB cells
Complete Blood Count (CBC) • • Hb concentration Hct RBC count RBC parameters WBC count WBC differential count Platelet count and parameters Description of blood smear
When to do CBC? • suspected hematologic, inflammatory, neoplastic, or infectious disease • screening of infants (<1 yr. ), pregnant women, elderly patients, and patients with nutritional abnormalities • routine patient evaluation, admission to hospital
Red blood cell (RBC) count • F: 3. 9 – 5. 0 x 1012 erythrocytes / L • M: 4. 5 – 5. 7 x 1012 erythrocytes / L
Number of RBC and quantity • decrease - anemia • increase - polycythemia = polyglobulia • Properties of RBC • * membrane • * hemoglobin • * metabolism
ANEMIA • WHO criteria: Hb < 125 g/L in adults • US criteria: – M: Hb < 135 g/L – F: Hb < 125 g/L
ANEMIA General sequlae of anemia less of hemoglobin impaired delivery of oxygen to the tissues tissue hypoxia fatigue, dyspnea, paleness. . . tachycardia hyperkinetic circulation
Hemoglobin concentration (Hb) and Hematocrit (Hct) • Depends on age and sex of the patient • Depends on hydratation of the patient (e. g. pregnancy) • F: Hb 121 -151 g/L Hct 36 -44% • M: Hb 138 -170 g/L Hct 41 -50% • Less then 70 g/L usually symptomatic tissue hypoxia
RBC parameters (indices) - 1 Differential diagnosis of anemias MEAN CORPUSCULAR VOLUME = MCV – MCV (f. L) = Hct / RBC count – Histological classification of anemias • microcytic anemia ( < 80 f. L) • normocytic anemia (80 – 95 f. L) • macrocytic anemia (> 95 f. L) – Not useful to detect anisocytosis = variation in cell size • Red Cell Distribution Width (RDW 11 - 15 %) – Reticulocytosis may increase MCV
RBC parameters (indices) - 2 MEAN CORPUSCULAR HEMOGLOBIN = MCH – MCH (pg/cell) = Hb / RBC count – MCH 32. 7 – 33. 7 pg / cell – Hypochromia MCH < 27 pg / cell MEAN CORPUSCULAR HEMOGLOBIN CONCENTRATION = MCHC – MCHC (g/L of RBC)= Hb / Hct – MCHC: 267 – 355 g / L
Types of anemias due to RBC parameters • • size: normocytic microcytic - smaller macrocytic (megaloblastic) – greater • • Hb content („colour“): normochromic hypochromic (decreased amount of Hb) hyperchromic (increased amount of Hb)
stem cells, growth factors erythropoetin BONE MARROW cell division: vitamin B 12, folic acid hemoglobin synthesis: globin, porphyrin, Fe other factors PRODUCTION hemolysis PERIPHERAL BLOOD LOSSES bleeding RED BLOOD CELL CBC hemoglobin, number or RBC, hematokrit MCV, MCHC shape etc.
Causes of anemia - due to decreased production -Stem cell disorder -DNA synthesis impaled -Hemoglobin synthesis impaled -Lack of erythropoietin • Complete loss of erythropoiesis result in decline of about 10% / wk - due to increased destruction -Erythrocyte defect -Extra-erythrocyte causes - due to increased loss - due to bad distribution (hyperslenism, pooling in spleen)
Activity of erythropoesis • number of reticulocytes (0. 5 -1. 5 %) • serum (solubile) transferrin receptor (s. Tf. R) – increased need for Fe • • • Low: suppression of hemopoiesis (erythropoiesis) High (reticulocytosis): activization after bleeding after hemolysis successful treatment of anemia etc.
Reticulocyte count • Daily RBC replacement – 0. 5 – 1. 5% of RBC count – Maturate within 1 day in peripheral blood • Criteria of marrow activity – Reticulocytosis • response to blood loss (hemolytic anemias, severe bleeding) • response to therapy of anemia (e. g. B 12 or Fe def. ) – Reticulocytopenia • deficient erythropoiesis (nutrient , hormonal, etc. )
Blood loss anemia • Acute blood loss – shortly after massive blood loss Hb normal due to vasoconstriction – normochromic - normocytic • Chronic blood loss – results in iron deficiency • Excessive hemolysis (RBC destruction)
Excessive hemolysis (RBC destruction) reticulocytosis, LDH is increased, unconjugated bilirubin accumulate Extrinsic RBC defect (normocytic-normochromic RBC ) • Immunologic abnormalities (AIHA, PNH) • Mechanical injury (trauma, infection) Intrinsic RBC defect • Membrane alterations – congenital (spherocytosis, elliptocytosis) – Aquired (hypophosphatemia) • Metabolic disorders (G 6 PD deficiency) • Hemoglobinopaties (Sicle cell disease, Thalassemia)
HEMOLYSIS INTRAVASCULAR Hb haptoglobin kidneys EXTRAVASCULAR spleen, bone marrow, liver (macrophages)
SYMPTOMS OF HEMOLYSIS loss of red blood cells loose Hb intravascular hemoglobinemia, hemoglobinuria hemosiderinuria anemia BM activation damage to the kidneys reticulocytosis extravascular increased prodution of bilirubin jaundice (icterus) splenomegaly
TESTS FOR HEMOLYSIS immune mechanisms – direct Search for antibodies against proper RBC Antibodies other than AB 0 These Abs are responsible for hemolysis Coombs (antiglobulin) test
Direct antiglobulin (Coombs’) test (DAT) • Detection of antibodies to erythrocyte surface antigens • AIHA • Antiglobulin serum is added to washed RBC from the patient ------ agglutination indicates presence of immunoglobulins or complement components bound to RBC
TESTS FOR HEMOLYSIS Test of osmotic resistence RBC survive only in isotonic surrounding but have some toleration to its changes RBC in some hemolytic states have decreased tolerance Special tests membrane properties (electrophoresis of proteins) properties of hemoglobin genetic tests
Acid hemolysis (Hams’) test • Diagnostic test for paroxysmal nocturnal hemoglobinuria (PNH) • HCl acidification of blood = hemolysis when PNH • Currently Flow cytometry analysis for CD 55 and CD 59 is more reliable to diagnose PNH • Glycosyl-phosphatidyl-anchor abnormality caused by the PIG-A gene mutation = clinical manifestation result from the lack of GPA dependent proteins on the surface of cells
Acid hemolysis (Hams’) test
Deficient erythropoiesis • Iron deficiency – microcytic-anisocytosis, ↓ reticulocytes • Vitamin B 12 or Folate deficiency – macrocytes-anisocytosis • BM failure - chronic diseases, aplastic anemia, myelodysplasia, leukemia – normochromatosis-normocytosis – BM hypoplasia
Tests for iron • • • iron concentration in serum (age , sex) TIBC (total iron binding capacity for Fe) transferrin saturation (N 20 -55 %) serum ferritin serum (solubile) transferrin receptor (s. Tf. R)
Tests of iron metabolism Serum iron ( SI) • F: 600 -1400 mg/L, 11 -25 mmol/L; M: 750 -1500 mg/L, 13 -27 mmol/L • Low in Fe deficiency and chronic disease • High in hemolytic syndromes and iron overload Total iron binding capacity (TIBC) • 2500 – 4500 mg/L , 45 -82 mmol/L • High in Fe deficiency • Low in chronic disease Serum ferritin (30 -300 ng/m. L) • Fe storage glycoprotein • Closely correlates with total body Fe stores • <12 ng/m. L Fe deficiency • Elevated in Fe overload, liver injury, tumors (Acute phase protein)
Tests for iron metabolism Serum transferin receptor • Increase in increased erythropoiesis and early Fe deficiency RBC ferritin • storage status over the previous 3 month (Fe deficiency/overload) • unaffected by liver function or acute illness Free RBC porphyrin • increased when heme synthesis altered
Manifest anemia Latent serum iron Tf saturation s. Tf. R iron deficiency erythropoiesis Prelatent no stores serum ferritin TIBC iron in BM
Microcytic Hypochromic Anemia (MCV<83; MCHC<31) Iron deficiency Chronic inflammation Thalassemia major Thalassemia minor Responsive to iron therapy Unresponsive to iron therapy Reticulocytosis and indirect bilirubinemia Elevation of fetal hemoglobin, target cells, and poikilocytosis Lead poisoning Basophilic stippling of RBCs Sideroblastic Ring sideroblasts in marrow Hemoglobinopaties Hemoglobin electrophoresis
Microcytic Hypochromic Anemia (MCV<83; MCHC<31) Serum Iron Lead poisoning N Sideroblastic Hemoglobinopaties N Total Iron. Binding Capacity (TIBC) N Bone Marrow Iron ++ Comment Basophilic stippling of RBCs N ++++ Ring sideroblasts in marrow N ++ Hemoglobin electrophoresis
Microcytic Hypochromic Anemia (MCV<83; MCHC<31) Serum Iron Total Iron. Binding Capacity (TIBC) 0 Iron deficiency Chronic inflammation Thalassemia major Thalassemia minor Bone Marrow Iron N N N Comment Responsive to iron therapy ++ Unresponsive to iron therapy ++++ Reticulocytosis and indirect bilirubinemia ++ Elevation of A of fetal hemoglobin, target cells, and poikilocytosis
Macrocytic Anemia (MCV, >95) Deficiency of vitamin B-12 Deficiency of folic acid Megaloblastic bone marrow Drugs affecting DNA synthesis Inherited disorders of DNA synthesis Liver disease Hypothyroidism and hypopituitarism Nonmegaloblastic Accelerated erythropoiesis (reticulocytes) bone marrow Hypoplastic and aplastic anemia Infiltrated bone marrow
Blood smear • Morphology of blood elements – Anisocytosis = variation in size – Poikilocytosis = variation in shape (schistocytes=RBC fragments; ovalocytes; spherocytes)
Various Forms of RBCs Spherocyte Loss of central pallor, stains more densely, often microcytic. Hereditary spherocytosis and certain acquired hemolytic anemias. Target cell Hypochromic with central "target" of hemoglobin. Liver disease, thalassemia, hemoglobin D, postsplenectomy. Elliptocyte Oval to cigar shaped. Hereditary elliptocytosis, certain anemias (particularly vitamin B-12 and folate deficiency). Schistocyte Fragmented helmet- or triangular-shaped RBCs. Microangiopathic anemia, artificial heart values, uremia, malignant hypertension. Stomatocyte Slitlike area of central pallor in erythrocyte. Liver disease, acute alcoholism, malignancies, hereditary stomatocytosis, and artifact. Sickle cell Elongated cell with pointed ends. Hemoglobin S and certain types of hemoglobin C and l.
Sicle Cell Disease
Hereditary sferocytosis
Peripheral blood film chronic myeloid leukemia basophils blast cell
WBC count • 4, 3 – 10, 8 x 109 / L • WBC differential count – Segmented neutrophils: 34 -75%; – Band neutrophils < 8%; – Lymphocytes: 12 – 50%; – Monocytes: 3 -15%; – Eosinophils < 5%; – Basophils < 3%.
Bone Marrow (BM) Analysis Aspiration usually from posterior iliac crest 0. 5 -2. 0 m. L Direct observation of bone marrow activity • Indication – Unexplained anemia and other cytopenias – Unexplained leukocytosis and thrombocytosis – Suspicion of leukemia and myeloproliferative diseases
BM Failure
BM - Cytogenetic Analysis Chromosomal abnormalities - AML, CML, MDS
Phases of chronic myeloid leukaemia
CML leukocytosis with the presence of precursor cells of the myeloid lineage blood film at 400 X
CML whole granulocytic lineage, including an eosinophil and a basophil blood film at 1000 X magnification
CML BM cells (400 X) demonstrates clear dominance of granulopoiesis
Philadelphia chromosome • Chromosome 22 often referred as Ph (95% of pts with CML) • Reciprocal translocation t(9; 22) – piece of chromosome 9 (c-abl) translocate to chromosome 22 (bcr) [BCR-ABL] and piece of 22 to 9 [ABL-BCR]. • BCR-ABL - constitutively active tyrosin-kinase • target for therapy (STI 571) – prognostic value – therapy response - Minimal Residual Disease
Philadelphia chromosome (Ph)
CML - FISH control DNA probes: • bcr (22 q 11. 2) in red • c-abl (9 q 34) in green. bcr/abl fusion present
The action of Imatinib Mesylate (STI 571, Gleevec) Goldman JM, Melo JV. N Engl J Med. 2001. 344: 1084 -1086.
Molecular analysis of BM and PB cells • measurement of gene expression or identification of mutations – Hemochromatosis - Hephestine – Monitoring of leukemia therapy: • AML: e. g. AML-ETO • CML: BCR-ABL
Immunophenotyping of BM or PB cells Flow cytometry (FACS): – suspected lymphoproliferative and myeloproliferative diseases (AML, CML) – diagnosis of PNH: • acquired hemolytic anemia due to a hematopoietic stem cell mutation defect • Harris test: GPI-anchored antigens are lacking from a portion of leukocytes, and usually erythrocytes in patients with PNH (e. g. CD 59)
Histochemical analysis of enzymatic activity in BM blasts • ALP – high in normal blasts / low in leukemia blasts • Peroxidase activity – leukemic blasts • Nonspecific esterase – monocytes (leuk. phenotype)
Functional tests - Clonogenic assay PV, Leukemia, MDS – cultivation of BM cells in semisolid media with growth factors – EPO independent BFU-E colonies P. Vera – CFU-GM/cluster ratio – decrease in leukemic hematopoiesis
Clonogenic assay CFU-GM BFU-E
Sensitivity of BFU-E progenitors to erythropoetin 100% PV (EEC) 75% PFCP 50% Normal EEC 25% 0% 0 30 60 125 EPO (m. U/ml) 250 3000
Scheme of normal and malignant hematopoiesis SRC Progenitors LTC-IC pluripotent determined AML SL-IC Diferenciated cells AML blasts AML-CFU
Hematopoietic Cells